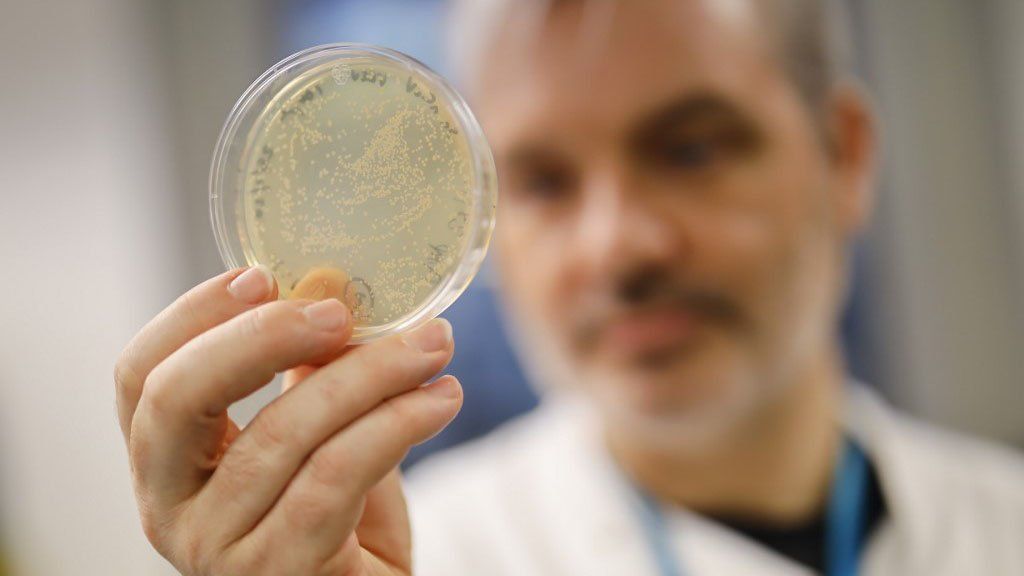
Reino Unido acusa a ciberespías de querer robar información sobre las vacunas por el COVID-19

"Mientras otros persiguen sus propios intereses con un comportamiento irresponsable, el Reino Unido y sus aliados están trabajando duro para encontrar una vacuna que proteja la salud de todos", agregó Raab.
Embed
Los ciberespías quisieron infiltrarse en el Imperial College de Londres (Foto: AFP)
Los ciberespías quisieron infiltrarse en el Imperial College de Londres (Foto: AFP).
La agencia británica contra el ciberespionaje determinó que los blancos de infiltración fueron los dos lugares que en el Reino Unido están en el desarrollo de una vacuna: la universidad de Oxford y el Imperial College de Londres.
La técnica de los hackers habría consistido en penetrar en el servicio de mails y en la VPN. Por medio del Virtual Private Network (VPN) se encripta información privilegiada o especial para que circule por internet sin ser interceptada o decodificada.
Las autoridades del ministerio de Relaciones Exteriores de Gran Bretaña creen que estos ciberpiratas no guardan relación con los que habrían intervenido en las últimas elecciones de los Estados Unidos.
Embed
Dominic Raab, el canciller británico alertó del espionaje por las vacunas(Foto: AFP)
Dominic Raab, el canciller británico alertó del espionaje por las vacunas (Foto: AFP).
Al mismo tiempo, los informes dados por la NCSC no pueden afirmar si el ciberataque fue exitoso a la hora de conseguir información sobre el desarrollo de las vacunas contra la pandemia.